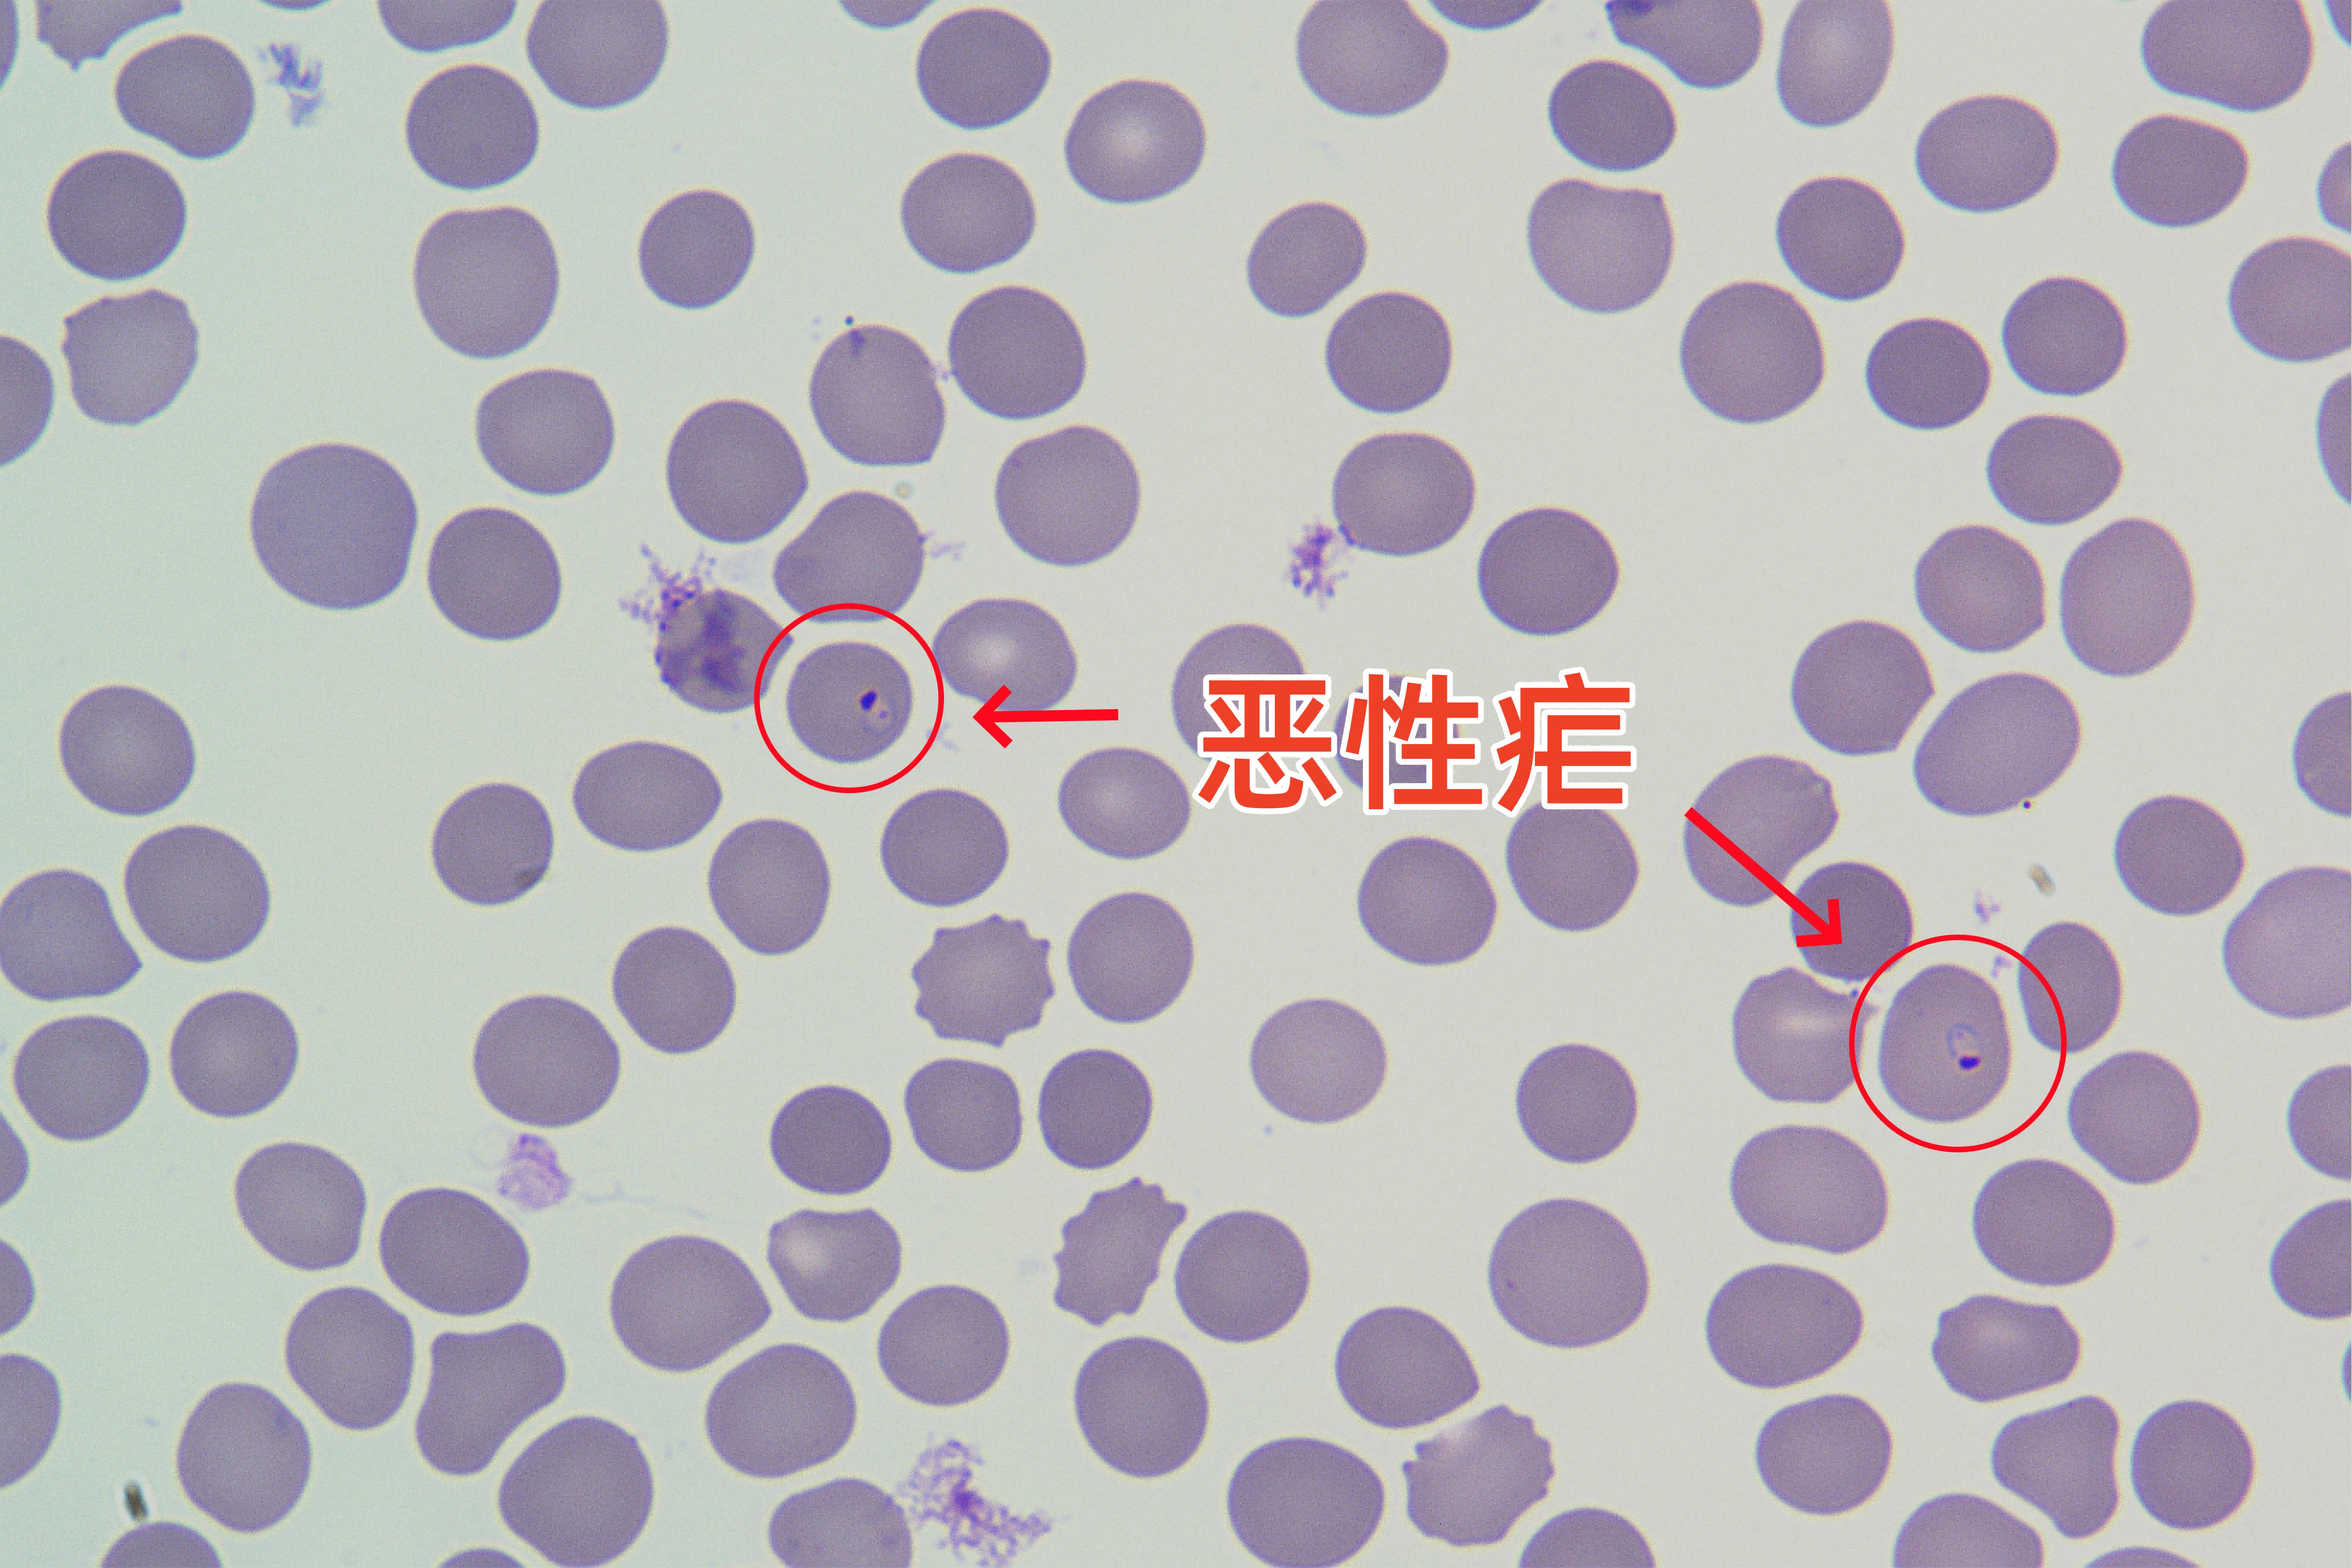

今天是: 福州市疾病预防控制中心欢迎您!
“黄昏时分,烟瘴大起,直至巳、午时方收,惟未、申、酉三时,可以往来;余者时辰,皆瘴气密布,触之即死”[1]。读过古典小说《三国演义》的朋友,应该对这段绘声绘色的描述印象深刻。这句话出现在诸葛亮南征孟获的情节中,描述的是云南地区的瘴气现象。
除了和自然因素有关,瘴气和生物因素如疟疾、沙虱病等疾病相关。例如,恶性疟疾在湿热环境中高发,患者会出现高热、昏迷等症状,被古人归为“瘴气致死”。

疟原虫在人群中以蚊虫为媒介传播,通过掠夺人体营养物质、刺激人体免疫系统过度反应、损害重要器官的功能等,给人体造成严重伤害。小说中描述的场景,发生于现在的云南省西部的临沧市境内。关于这种疾病,与其相邻的西双版纳傣族自治州,更有民谣生动地描述其危害:“十人到勐腊,九人难回家;要到车佛南(即现今的景洪、勐海、勐遮),首先买好棺材板;要到菩萨坝,先把老婆嫁”[2]。
疟疾共有恶性疟、间日疟、卵形疟和三日疟4种类型。导致患者死亡的主要为恶性疟原虫感染引起的恶性疟,也是古时“瘴气”的罪魁祸首。

(显微镜-厚血膜镜下图像,图片为原创,若引用,请标明出处)
(显微镜-薄血膜镜下图像,图片为原创,若引用,请标明出处)
在人类文明的列车驶入了先进的21世纪,恶性疟还这么恶吗?
答案是肯定的。《2024年WHO世界疟疾报告》显示:2022年估测全球疟疾病例数约2.49亿,死亡病例约60.8万例。其中70%以上的死亡病例为非洲5岁以下儿童,且几乎均为恶性疟[3]。 我国于2021年通过了世界卫生组织的消除疟疾认证(即在我国境内已不存在疟原虫在人群间的传播),小说中描述的情景将只会出现在文字里了。但需要注意的是,我国每年仍有近3000例的输入病例(恶性疟占比50%以上),并报告数十例的危重病例及十例左右的死亡病例,后者均为恶性疟原虫感染者[4]。
那恶性疟为何至今依然如此险恶?其到底恶在哪里?
1.疫苗研发艰难
疟疾虽然是一种古老的传染病,但其疫苗研发却比天花、新型冠状病毒、黄热病等病毒类疾病艰难。这是因为疟疾患者痊愈后,不会获得终生免疫力。即使是短时间的免疫作用,有时也因疟原虫种类和株系的不同,对再次侵染的疟原虫不能达到较高水平免疫,甚至无免疫[5]。这一特性,致使其能危害至今,且对儿童尤为不友好。对于已经消除疟疾的地区,除近期曾在疟疾疫区得过疟疾的个别人群外,我国绝大多数人对疟疾无免疫力,均为易感人群。当他们去到疟疾流行区,被唾液中含疟原虫的蚊虫叮咬后,依靠免疫力成功抵抗疟疾的可能性几乎为0。
2.疟原虫会聚集在脑血管,对人体伤害严重
恶性疟之恶,还在于恶性疟原虫可能会在脑血管中聚集,使红细胞和血管内皮细胞发生粘连,造成脑部微血管阻塞及局部缺氧,使患者出现中枢神经系统功能紊乱(脑型疟,重症疟疾之一),是儿童和无免疫力成人的主要死亡原因[5]。这种情况在其他种类疟疾患者中甚少见到。
可喜的是,疟疾疫苗的研发近期有了重大突破,完成了三期临床试验的RTS,S/AS01疟疾疫苗,可显著降低儿童临床疟疾、重症疟疾及严重的疟疾贫血等。不过,目前世界卫生组织仅推荐在疟疾中、高流行国家或地区的儿童中接种应用[6]。
参考文献
1.罗贯中. 三国演义:第八十九回《武乡侯四番用计,南蛮王五次遭擒》 [M].北京:人民文学出版社,2022.
2.叶寒,刘炜. 诗意中国-09屠呦呦:青蒿一握,她让我们懂得何为中国脊梁.https://www.163.com/dy/article/FJO5GS430521KK2L.html. 2020-08-11 10:53.
3.World Health Organization. World malaria report. xvii-xix. Geneva: WHO; 2024.
4.张丽,夏志贵.2023年全国疟疾疫情分析[J].中国寄生虫学与寄生虫学病杂志,2024,42(2):135-139.
5.诸欣平, 苏川. 人体寄生虫学(第9版)[M]. 北京: 人民卫生出版社, 2018: 57-68.
6.World Health Organization. Guidelines for malaria. 133-136 and 178-179. Geneva: WHO; 2022.
来源:中国疾病预防控制中心 中国寄生虫病与热带病防控
注:本文部分图片来自网络,非商业用途,仅作科普使用,如有风险或侵权,请及时联系删除。
供稿:急性传染病防控科
一审:姚丽钦
二审:詹文青
三审:罗柏友
Copyright 2009 福州市疾病预防控制中心 All Rights Reserved
福州市疾病预防控制中心 主办
公安备案号:35010202001851 闽ICP备11009988号
联系方式:0591-63039912 | 隐私保护